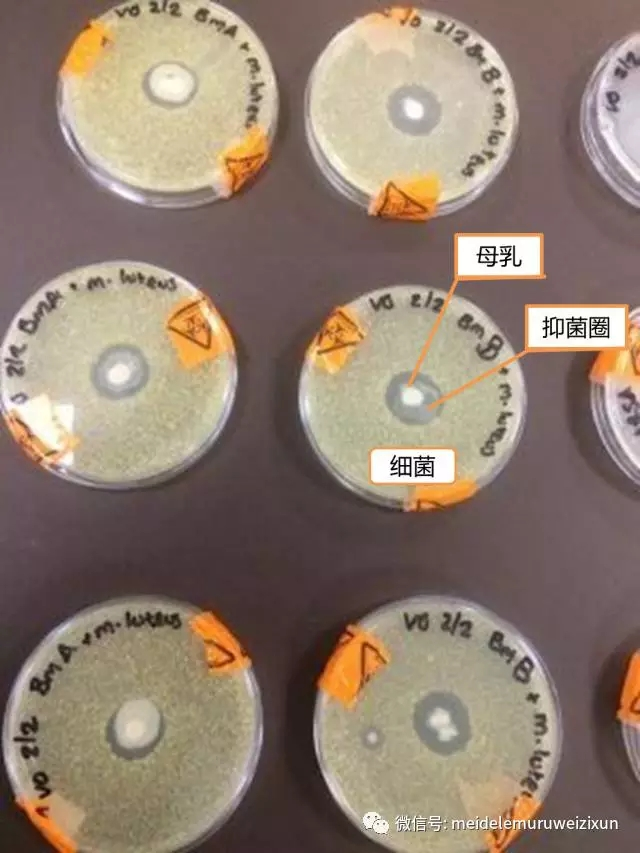

12个月后奶水就没营养了?这样回应!
2018-08-09 14:04:47

周一下午,我们妈妈群里的牛牛妈私信我:15个月的牛牛去体检,身高体重相比12个月的时候基本没动(之前一直超重,身高约76厘米,体重23斤)。回家后,公婆都急了,要她断奶,改成奶粉,说是母乳到15个月已经没有营养了,还是奶粉营养好。牛牛妈原本准备母乳牛牛到两岁,现在不知道如何回答公婆,特来求助。
说实话,听到这个消息还是蛮开心的,象妈妈这个支持母乳喂养的居家母婴服务品牌实际运营两年,很多最早期的客户还一直在母乳喂养,让我们很欣慰。前两天,在上海母乳喂养宣传周上看到的数字是:全国6个月以下宝宝的母乳喂养率还只有21%,而据我们粗略统计,象妈妈服务的妈妈母乳喂养率超过60%,单就这一点而言,象妈妈就有存在的意义和价值。
回到牛牛妈的问题上来,15个月的母乳是否真的没有营养了?民间说法,来了月经后,母乳就没有营养了,是否科学?世界卫生组织建议喂到2岁背后的原因究竟是什么?
No.1
宝宝12个月了,母乳就没有营养了?
2016年,Maternal & Child Nutrition刊登了一篇文章,研究了产后第二年(哺乳期11个月-哺乳期17个月)母乳的成分,结果显示:
1、 产后11-17月间母乳中的总蛋白质、乳铁蛋白、溶菌酶、IgA、钠、寡聚糖含量增加。
2、产后11-17月间的母乳中锌、钙含量略降低,约每个月降低5%。但这些元素可通过辅食获得。
3、其他成分的波动更多源于个体差异而非时间影响。
4、 产后11-17月间的母乳,宏量成分与产后1年内的成熟乳比较,其含量稳丁甚至更高。
纯母乳喂养6个月后,宝宝开始添加辅食。随着辅食的添加,母亲乳量会逐渐降低,母乳中的营养成分浓度会上升。
因此可认为:母乳成分是根据宝宝生长发育所需而进行变化的。
如果有公婆觉得母乳不及配方奶,可以直接把下面的图片发给他看。

母乳中含有400多种营养成份,而且每时每刻都在随着宝宝的需求变化,是宝宝很好的食品,甩出配方奶不知多少条街。
注意看图表右下角小字:
母乳根据您宝宝的成长需要在随时变化,“第二年妈妈分泌的乳汁显著提高了脂肪含量和能量,血清素和溶解酵素也在不断增加……离乳期间,随着奶量下降,保护因子在乳汁中所占的分例和重要程度都增加了,并为孩子和妈妈的乳房在整个泌乳期间都提供了保护。”
——《哺乳顾问实践的核心课程》
No.2
一岁后的母乳更有抗感染能力
母乳中的抗体在整个母乳喂养过程中都是很丰富的。事实上,母乳中的免疫因子的浓度在第二年,和断奶的过程中,因为奶量下降,都会变得更高(更浓缩了)。一岁后的母乳包含了更高浓度的乳铁蛋白,溶菌酶和免疫球蛋白A(Perrin 2016)。这些成分和孩子的免疫力有关。
Vicky Green是3个孩子的妈,读生物科学专业。她对母乳保护孩子免受感染很感兴趣,就把稀释处理后的条件致病菌——藤黄微球菌(能引起伤口感染)涂在培养基(它的食物)上,然后在培养基的正中间滴一滴母乳。她分别滴了一个15个月和一个三年的母乳喂养妈妈的乳汁,结果,她发现——
图中的白点:母乳;浅黄色物质:成片的藤黄微球菌落;透明/白色的圈:抑菌圈,在这个圈内细菌不能生长。
什么是抑菌圈?就是让感染菌不能近身!圈越大,战斗力越强,母乳的抑菌能力越强。
此外,她还用大肠杆菌(能引起严重腹泻和败血症)和MRSA(造成乳腺炎、脓肿的细菌)进行此实验,同样能产生这样的效果。
母乳中的什么物质发挥抑菌作用呢?母乳中的乳铁蛋白、溶菌酶、防御素、白细胞、抗体等具有抑菌效果。也被称为“抑菌因子”。初乳以及早产妈妈的乳汁中“抑菌因子”含量更高。母乳对于早产儿来说几乎是一种“救命灵药”。
从图中可以看出,15个月的母乳和3年后的母乳抑菌圈大小差不多,也就是说抑菌效果相似。
谁说3年后母乳就成白开水了,明明还有强大的“抑菌因子”!
为啥三年后的母乳还有如此效力呢?因为,虽然宝宝添加辅食后母乳的量会下降,但是母乳中营养成分的浓度会升高。
No.3
母乳喂养有助于孩子的智力发育
如果以上两点还没有把公婆征服,那就来杀手锏——母乳喂养时间长的宝宝,智力发育水平也越高。
大量的、广泛的研究都发现母乳喂养得久的孩子有更好的认知发展。
提出这个观点是英国助产士联盟,而且写进了给每一个英国妈妈的教育手册里。
当然,你也可以说,决定智力的更主要是基因,但既然有这样的可能性,为什么不为宝宝争取一下呢?
至于持续的母乳喂养对宝宝情感、心理需求的帮助,就不再详细解说了,1岁以后要不要母乳喂养,还是看看权威机构都怎么说——

只要妈妈和宝宝愿意,母乳喂养应该至少持续一年以上……延长母乳喂养能给妈妈和孩子带来重要的健康和发展优势……母乳喂养的时间没有上限,没有证据表明三岁以后还继续母乳喂养会对孩子的心理或发展带来危害。
(AAP 2012, AAP 2005)
世界卫生组织:
有研究表明,哺乳2.5到7年,是人类宝宝生物学设计上应该达到的时间。孩子们断奶的年龄各不相同,哪怕只喝了很短时间的母乳,也算有过最好的开始。只要断奶是你认为最好的决定,尽管去做。但是,如果有人说你的母乳没有营养了,应该断奶了,那是对母乳的偏见。
母乳喂养医学会:
提前断奶的做法反而可能是有害的。人类母乳含有营养,抗体和调节成分。更长的母乳喂养时间可能降低乳腺癌,子宫癌,糖尿病,肥胖,心脏病,高血压。
每年的8月1日至7日是世界母乳喂养周,
今年的主题是:







